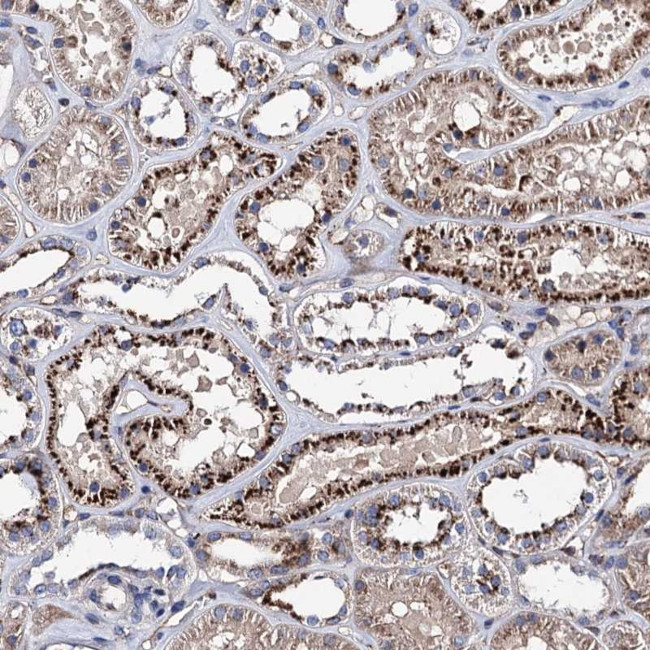
RISC Antibody in Immunohistochemistry (Paraffin) (IHC (P))

Search
Invitrogen
RISC Polyclonal Antibody
{{$productOrderCtrl.translations['antibody.pdp.commerceCard.promotion.promotions']}}
{{$productOrderCtrl.translations['antibody.pdp.commerceCard.promotion.viewpromo']}}
{{$productOrderCtrl.translations['antibody.pdp.commerceCard.promotion.promocode']}}: {{promo.promoCode}} {{promo.promoTitle}} {{promo.promoDescription}}. {{$productOrderCtrl.translations['antibody.pdp.commerceCard.promotion.learnmore']}}
产品信息
PA5-83448
种属反应
宿主/亚型
分类
类型
抗原
偶联物
形式
浓度
规格
纯化类型
保存液
内含物
保存条件
运输条件
RRID
产品详细信息
Immunogen sequence: KPVISIVDEL LEAGINVTVY NGQLDLIVDT MGQEAWVRKL KWPELPKFSQ LKWKALYSDP KSLETSAFVK SYKNLAFYWI LKAGHMVPSD QGDMALKMMR LVTQQ
Highest antigen sequence indentity to the following orthologs: Mouse - 82%, Rat - 85%.
靶标信息
The RNA-induced silencing complex (RISC) is a key player in the regulation of gene expression through RNA interference (RNAi) mechanisms. It operates by utilizing small RNA molecules-such as microRNAs (miRNAs), small interfering RNAs (siRNAs), and PIWI-interacting RNAs (piRNAs)-which are processed from double-stranded RNA precursors by enzymes like Drosha and Dicer in animals, and DICER-LIKE in plants. RISC is a versatile molecular complex consisting of Argonaute proteins as its core component, which guides the complex to the target RNA by complementary base pairing. Once assembled, RISC can recruit other proteins that mediate gene silencing by degrading or inhibiting the translation of the target RNA. This post-transcriptional regulation system is integral to numerous biological processes, allowing cells to control gene expression finely and respond to endogenous and exogenous signals. The functionality of RISC in gene silencing highlights its significance in the broader context of genetic regulation and has implications in therapies that target gene expression through RNAi.
仅用于科研。不用于诊断过程。未经明确授权不得转售。
篇参考文献 (0)
生物信息学
蛋白别名: Retinoid-inducible serine carboxypeptidase; retinoid-inducible serine caroboxypeptidase; retinoid-inducible serine caroboxypetidase; Serine carboxypeptidase 1; serine carboxypeptidase 1 precursor protein; serine caroboxypeptidase 1; unnamed protein product
基因别名: 2410018F01Rik; 4833411K15Rik; AI957256; HSCP1; MSTP034; RISC; SCP1; SCPEP1; UNQ265/PRO302
UniProt ID: (Human) Q9HB40, (Mouse) Q920A5, (Rat) Q920A6
Entrez Gene ID: (Human) 59342, (Mouse) 74617, (Rat) 114861